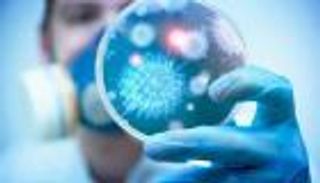
مشروب يقي من عدوى كورونا.. موجود في كل منزل

"مخاط الفيروس".. سر عدم الإصابة بكورونا من الأسطح الملوثة

توصلت دراسة حديثة إلى أن عدم قدرة الفيروسات التاجية العالقة بالأسطح على الإصابة بالعدوى ترجع إلى المخاط الذي يحيط بها.
تسببت جائحة فيروس كورونا المستجد في حالة من الذعر لدى سكان العالم في أوائل عام 2020 ما جعلهم يبالغون في عمليات التعقيم لتجنب التقاط العدوى، ولكن بعد مرور عامين، بات العلماء يؤكدون أن الفيروس الذي يسبب عدوى كوفيد-19 ينتشر بشكل أساسي من خلال قطرات الجهاز التنفسي التي تنتشر في الهواء وليس من خلال الأسطح الملوثة.
والآن توصلت دراسة حديثة إلى سبب تراجع قدرة الفيروسات التاجية العالقة على الأسطح على الإصابة بالعدوى، إذ وجدت أن الأمر يرجع إلى المخاط الذي يحيط بالفيروس، وفقاً لموقع "Study Finds" الأمريكي.

وأظهرت الدراسة أنه على الرغم من أن فيروسات كورونا يمكن أن تبقى على الأسطح لأيام أو أسابيع، فإن لمس هذه الأسطح في الغالب لا يؤدي لالتقاط العدوى، وذلك لأن الفيروسات تخرج من الشخص المصاب مُغطاة بالمخاط الذي يحتوي على جزيئات سكر تمنع الفيروس من إصابة الخلايا الأخرى.
وأجريت الدراسة لمعرفة كيف يمكن للمخاط منع الفيروس من التسبب في الإصابة بعد وجوده لفترات طويلة على الأسطح، ويقول الباحثون إن المخاط يحتوي على بروتينات تسمى الميوسين والتي تحتوي على جزيئات السكر المعروفة باسم الجليكانات، والتي تعد مهمة لأن بروتينات سبايك الموجودة في الفيروس عادة ما تستهدف جزيئات السكر الموجودة على سطح الخلية لإصابتها، ولذا فإنه في حال أصبحت بروتينات سبايك مغطاة بالجليكانات الموجودة في المخاط، فإنها لن ترتبط بتلك الموجودة على أسطح الخلايا وفي هذه الحالة لن تحدث الإصابة.
وفي الدراسة، التي نُشرت نتائجها في مجلة "ACS Central Science"، استخدم الباحثون نسخة وهمية من فيروس كورونا البشري أطلقوا عليها اسم "OC43"، ووضعوا قطرات منها في وسط نمو يحتوي على 0.1-0.5٪ من المخاط كان عالقاً على سطح بلاستيكي، ثم قاموا بقياس قدرتها على إصابة الخلايا.
ووجد الباحثون أن قدرة الفيروسات التي كانت مغطاة بالمخاط على العدوى تراجعت بشكل كبير للغاية، كما وجدوا أيضاً نتائج مماثلة عندما جاء المخاط من أسطح فولاذية وزجاجية وكذلك العينات التي تم جلبها من الكمامات الجراحية.